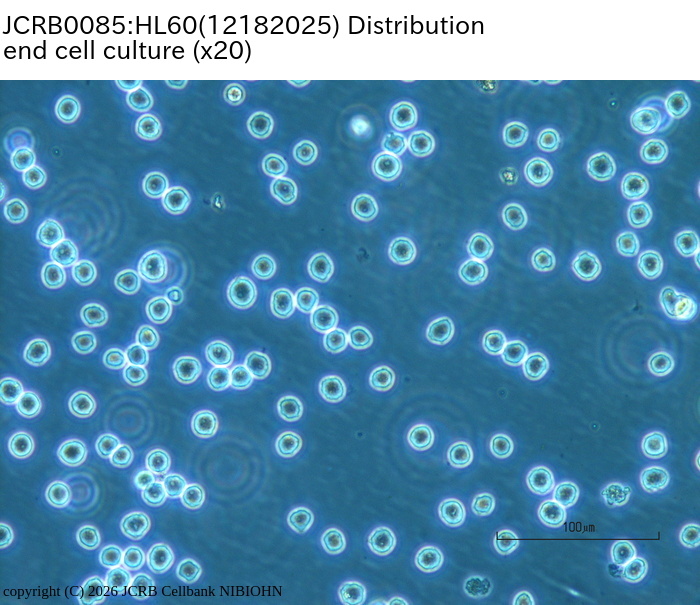

JCRB0085 HL60
細胞情報
Important Notice(s)The cultivation of HL60: Tips for recovery.
細胞種類:一般細胞 (細胞分譲手数料はこちら)
| 細胞番号(JCRB) | JCRB0085 | 細胞名 | HL60 |
|---|---|---|---|
| 生物種(日本語) | ヒト | 組織名(日本語) | 血球・リンパ系 |
| コメント(日本語) | 白血病, 急性前骨髄球性, 分化誘導可能 | プロフィール | Promyelocytic cell line differentiated to neutrophils or macropahges by tumor promoters, vitamne D3 or cytekines. The cell line can be used for the research of the differenciation induction or analysis of some oncogenes. |
| 別名 | HL-60 | 動物名 | human |
| 系統名 | 学名・属名 | Homo | |
| 学名・種小名 | sapiens | 性別 | F |
| 年齢・月齢 | 36 | 細胞識別情報 | available |
| (癌)原発組織名 | hemo-lymphocytic | 病歴情報 | acute promyelotic leukemia |
| 転移の有無(Y/N) | (癌)転移組織名 | ||
| 遺伝的性質 | APL | 細胞寿命 | infinite |
| クライシスPDL | 形態 | lymphocyte-like | |
| 一般性状 | DMSO,butyl.,HX.,TPA,act.D,& R.A. ind. differentiat | 細胞分類 | tumor |
| 細胞樹立者名 | Collins,S.J. et al. | 細胞寄託者 | Hozumi,M. |
| 分譲時制限 | free | コメント | Doubling time is 40hr. Growth is not so good from thawing to 1 month. Inoculate about 10^6 cells to 60mm dish when thawing. STR-PCR indicated the HL60 is same as HL60(S) (JCRB0163), |
| 入手年 | 1986 | 培養培地 | RPMI1640 medium with 20% fetal calf serum. |
| 継代方法 | Simple dilution. | 継代時細胞数 | |
| 人種 | Cocasian | 炭酸ガス濃度 | 5 % |
| 採取組織名 | peripheral blood | 組織型 |
| ウイルスDNA・RNA検出検査 (Detection of virus genome fragment by Real-time PCR) | |||||||||
|---|---|---|---|---|---|---|---|---|---|
| ウイルスDNA 検出検査 |
tested | ウイルスRNA 検出検査 |
tested | ||||||
| CMV | - | parvoB19 | - | HCV | - | HTLV-1 | - | ||
| EBV | - | HBV | - | HIV-1 | - | HTLV-2 | - | ||
| HHV6 | - | HTLV-1 | - | HIV-2 | - | HAV | - | ||
| HHV7 | - | HTLV-2 | - |
-/negative. +/positive. nt/not tested. (positive (+) does not immediately mean the production of infectious viral particles.) |
|||||
| BKV | - | HIV-1 | - | ||||||
| JCV | - | HIV-2 | - | ||||||
| ADV | - | HPV18 | - | ||||||
| Notes | |||||||||
| Reference | |
|---|---|
| Pubmed id:10470292 | Contribution of the nucleoside transport system to doxorubicin transport in HL60 cells but not in mononuclear cells. Nagasawa K,Fumihara T,Ohnishi N,Yokoyama T Jpn J Cancer Res. 1999 Jul;90(7):781-7 |
| Pubmed id:6192693 | Fundamentals of chemotherapy of myeloid leukemia by induction of leukemia cell differentiation. Hozumi M Adv Cancer Res. 1983;38():121-69 |
| Pubmed id:288488 | Characterization of the continuous, differentiating myeloid cell line (HL-60) from a patient with acute promyelocytic leukemia. Gallagher R,Collins S,Trujillo J,McCredie K,Ahearn M,Tsai S,Metzgar R,Aulakh G,Ting R,Ruscetti F,Gallo R Blood. 1979 Sep;54(3):713-33 |
| Pubmed id:271272 | Continuous growth and differentiation of human myeloid leukaemic cells in suspension culture. Collins SJ,Gallo RC,Gallagher RE Nature. 1977 Nov 24;270(5635):347-9 |
| Images |
|---|
            |
LOT Information
生細胞率、増殖速度、細胞濃度はバンクでのロット作製時の実測値として記していますが、保証値ではございません。また、倍加時間は継代間で計測したラフな値です。Viability/Growth rate/Cell number are represented as actual values measured at lot presentation in JCRB, but are not guaranteed values. Additionally, the doubling time is a rough value measured during passages.
- 08192010
- 04282009
- 11182005
- 11062001
- 042197
- 051496
- 031495
- 073093
- 080493
- 080593
- 091792
- 042092
- 062091
- 090790
- 051590
- 101189
- 080687
- 043097
- 02082016
- 02152018
- 04092019
- 07072022
- 02122025
- 12182025
| 細胞番号 | JCRB0085 | 細胞名 | HL60 |
|---|---|---|---|
| 培養ロット番号 | 08192010 | 培養種別 | distribution |
| 培地 | RPMI1640 medium with 10% fetal bovine serum (GIBCO 10099). Use 20% FBS until cell growth becomes log phase. | 培養温度 | 37 C |
| 継代時細胞数(濃度) | 1 - 3 x 10^5 cells/ml | 継代方法 | dilution (解凍時はフラスコを傾けて細胞を角に集めて培養すると増殖の立ち上がりが早いです) |
| 増殖速度 | 凍結時生細胞濃度 | 1.1 x 10^6 | |
| 凍結時生細胞率 | 79 | 使用抗生物質 | free |
| 継代数 | Unknown (10 at bank) | PDL数(プライマリ) | |
| マイコプラズマ検出 | - | 細菌汚染検出 | - |
| 真菌汚染検出 | - | アイソザイム検査・動物名 | Confirmed as human by NP, G6PD (type B), MD. |
| 染色体モード | 染色体情報 | ||
| 表面抗原 | DNA Profile (STR) | ||
| 接着性 | No | 導入外部遺伝子 | |
| 凍結培地 | 10% DMSO, 20% FBS - RPMI1640 | 炭酸ガス濃度 | 5% |
| 解凍後生細胞率 | 79 | 追加情報 |
| 細胞番号 | JCRB0085 | 細胞名 | |
|---|---|---|---|
| 培養ロット番号 | 04282009 | 培養種別 | distribution |
| 培地 | RPMI1640 medium with 10% fetal bovine serum (GIBCO 10099). Use 20% FBS until cell growth becomes log phase. | 培養温度 | 37 C |
| 継代時細胞数(濃度) | 1 - 3 x 10^5 cells/ml | 継代方法 | dilution (解凍時はフラスコを傾けて細胞を角に集めて培養すると増殖の立ち上がりが早いです) |
| 増殖速度 | 凍結時生細胞濃度 | 4.8 x 10^6 | |
| 凍結時生細胞率 | 92.5 | 使用抗生物質 | free |
| 継代数 | Unknown (12 at bank) | PDL数(プライマリ) | |
| マイコプラズマ検出 | - | 細菌汚染検出 | - |
| 真菌汚染検出 | - | アイソザイム検査・動物名 | Confirmed as human by NP, G6PD (type B), MD. |
| 染色体モード | 染色体情報 | ||
| 表面抗原 | DNA Profile (STR) | ||
| 接着性 | No | 導入外部遺伝子 | |
| 凍結培地 | 10% DMSO, 20% FBS - RPMI 1640 | 炭酸ガス濃度 | 5% |
| 解凍後生細胞率 | 追加情報 |
| 細胞番号 | JCRB0085 | 細胞名 | |
|---|---|---|---|
| 培養ロット番号 | 11182005 | 培養種別 | distribution |
| 培地 | RPMI1640 medium with 10% fetal bovine serum (FBS lot; GIBCO 4218333S). Use 20% FBS until cells growth becomes log phase. | 培養温度 | 37 C |
| 継代時細胞数(濃度) | 1.5 - 3 x 10^5 cells/ml. | 継代方法 | dilution (解凍時はフラスコを傾けて細胞を角に集めて培養すると増殖の立ち上がりが早いです) |
| 増殖速度 | 30-40 hrs | 凍結時生細胞濃度 | 9.3 x 10^5 |
| 凍結時生細胞率 | 92 | 使用抗生物質 | free |
| 継代数 | Unknown (12 at bank) | PDL数(プライマリ) | |
| マイコプラズマ検出 | - | 細菌汚染検出 | - |
| 真菌汚染検出 | - | アイソザイム検査・動物名 | |
| 染色体モード | 染色体情報 | ||
| 表面抗原 | DNA Profile (STR) | ||
| 接着性 | No | 導入外部遺伝子 | |
| 凍結培地 | 10% DMSO, 20% FBS - RPMI1640 | 炭酸ガス濃度 | 5% |
| 解凍後生細胞率 | 追加情報 |
| 細胞番号 | JCRB0085 | 細胞名 | |
|---|---|---|---|
| 培養ロット番号 | 11062001 | 培養種別 | distribution |
| 培地 | RPMI1640 medium with 20% fetal bovine serum(非働化を推奨。対数増殖期は10%で培養可能) | 培養温度 | 37 C |
| 継代時細胞数(濃度) | 1.5-3.0 x 10^5 cells/ml | 継代方法 | dilution. 解凍直後は5mlの培地, FBS 20%, フラスコを傾けて培養すると立上りが良好 |
| 増殖速度 | D.T. = ca 40 hrs | 凍結時生細胞濃度 | 3.0 x 10^6 |
| 凍結時生細胞率 | 87.0 | 使用抗生物質 | free |
| 継代数 | P12* | PDL数(プライマリ) | |
| マイコプラズマ検出 | - | 細菌汚染検出 | - |
| 真菌汚染検出 | - | アイソザイム検査・動物名 | |
| 染色体モード | 染色体情報 | ||
| 表面抗原 | DNA Profile (STR) | ||
| 接着性 | 導入外部遺伝子 | ||
| 凍結培地 | 10% DMSO, 20% FBS-RPMI1640 | 炭酸ガス濃度 | |
| 解凍後生細胞率 | 追加情報 |
| 細胞番号 | JCRB0085 | 細胞名 | HL60 |
|---|---|---|---|
| 培養ロット番号 | 042197 | 培養種別 | distribution |
| 培地 | RPMI1640 medium with 10% or 20% heat inactivated fetal bovine serum (Cell Culture T.1604309). | 培養温度 | 37 C |
| 継代時細胞数(濃度) | 2x10^5 cells/ml | 継代方法 | Simple dilution, because of a suspension culture. |
| 増殖速度 | NT | 凍結時生細胞濃度 | 1.93x10^6 |
| 凍結時生細胞率 | 96.3 | 使用抗生物質 | free |
| 継代数 | P10* | PDL数(プライマリ) | NT |
| マイコプラズマ検出 | - | 細菌汚染検出 | - |
| 真菌汚染検出 | - | アイソザイム検査・動物名 | NT |
| 染色体モード | NT | 染色体情報 | Under investigation. |
| 表面抗原 | NT | DNA Profile (STR) | |
| 接着性 | No | 導入外部遺伝子 | NT |
| 凍結培地 | Culture medium with 5% DMSO. | 炭酸ガス濃度 | |
| 解凍後生細胞率 | 追加情報 |
| Images |
|---|
  |
| 細胞番号 | JCRB0085 | 細胞名 | HL60 |
|---|---|---|---|
| 培養ロット番号 | 051496 | 培養種別 | distribution |
| 培地 | 培養温度 | ||
| 継代時細胞数(濃度) | 継代方法 | ||
| 増殖速度 | 凍結時生細胞濃度 | ||
| 凍結時生細胞率 | 使用抗生物質 | ||
| 継代数 | PDL数(プライマリ) | ||
| マイコプラズマ検出 | - | 細菌汚染検出 | - |
| 真菌汚染検出 | - | アイソザイム検査・動物名 | |
| 染色体モード | 染色体情報 | ||
| 表面抗原 | DNA Profile (STR) | ||
| 接着性 | 導入外部遺伝子 | ||
| 凍結培地 | 炭酸ガス濃度 | ||
| 解凍後生細胞率 | 追加情報 |
| Images |
|---|
    |
| 細胞番号 | JCRB0085 | 細胞名 | HL60 |
|---|---|---|---|
| 培養ロット番号 | 031495 | 培養種別 | distribution |
| 培地 | RPMI1640 medium with 20% heat inactivated fetal bovine serum (JRS.DO10400) | 培養温度 | 37 C |
| 継代時細胞数(濃度) | 2-5x10^5 cells/ml | 継代方法 | dilution |
| 増殖速度 | NT | 凍結時生細胞濃度 | 2.9x10^6 |
| 凍結時生細胞率 | 92.8 | 使用抗生物質 | free |
| 継代数 | P7* | PDL数(プライマリ) | NT |
| マイコプラズマ検出 | - | 細菌汚染検出 | - |
| 真菌汚染検出 | - | アイソザイム検査・動物名 | NT |
| 染色体モード | NT | 染色体情報 | NT |
| 表面抗原 | NT | DNA Profile (STR) | |
| 接着性 | No | 導入外部遺伝子 | NT |
| 凍結培地 | 炭酸ガス濃度 | ||
| 解凍後生細胞率 | 追加情報 |
| 細胞番号 | JCRB0085 | 細胞名 | HL60 |
|---|---|---|---|
| 培養ロット番号 | 073093 | 培養種別 | distribution |
| 培地 | RPMI1640 medium with 20% fetal bovine serum (Hyclone lot.1151031) | 培養温度 | 37 C |
| 継代時細胞数(濃度) | 2-5x10^5 cells/ml | 継代方法 | Cells are simply diluted with fresh medium. |
| 増殖速度 | 86.6hr->51.4hr | 凍結時生細胞濃度 | 3.6x10^6 |
| 凍結時生細胞率 | 81.3 | 使用抗生物質 | free |
| 継代数 | P13* | PDL数(プライマリ) | NT |
| マイコプラズマ検出 | - | 細菌汚染検出 | - |
| 真菌汚染検出 | - | アイソザイム検査・動物名 | LDH,G6PD,NP G6PD=type B |
| 染色体モード | NT | 染色体情報 | NT |
| 表面抗原 | NT | DNA Profile (STR) | |
| 接着性 | No | 導入外部遺伝子 | NT |
| 凍結培地 | 炭酸ガス濃度 | ||
| 解凍後生細胞率 | 追加情報 |
| 細胞番号 | JCRB0085 | 細胞名 | HL60 |
|---|---|---|---|
| 培養ロット番号 | 080493 | 培養種別 | distribution |
| 培地 | RPMI1640 medium with 20% fetal bovine serum (JRH Biosciences Lot.1B1062) | 培養温度 | 37 C |
| 継代時細胞数(濃度) | 2-3x10^5 cells/ml | 継代方法 | Cells are simply diluted by the fresh medium. |
| 増殖速度 | Td=45.2-52.2hrs | 凍結時生細胞濃度 | 4.3x10^6 |
| 凍結時生細胞率 | 78.3 | 使用抗生物質 | free |
| 継代数 | P14* | PDL数(プライマリ) | NT |
| マイコプラズマ検出 | - | 細菌汚染検出 | - |
| 真菌汚染検出 | - | アイソザイム検査・動物名 | NT |
| 染色体モード | NT | 染色体情報 | NT |
| 表面抗原 | NT | DNA Profile (STR) | |
| 接着性 | No | 導入外部遺伝子 | NT |
| 凍結培地 | 炭酸ガス濃度 | ||
| 解凍後生細胞率 | 追加情報 |
| 細胞番号 | JCRB0085 | 細胞名 | HL60 |
|---|---|---|---|
| 培養ロット番号 | 080593 | 培養種別 | distribution |
| 培地 | RPMI1640 medium with 20% fetal bovine serum (JRH Biosciences, lot.1B1062) | 培養温度 | 37 C |
| 継代時細胞数(濃度) | 2-3x10^5 cells/ml | 継代方法 | Cells are diluted with fresh medium. |
| 増殖速度 | NT | 凍結時生細胞濃度 | 2.8x10^6 |
| 凍結時生細胞率 | 84.5 | 使用抗生物質 | free |
| 継代数 | P14* | PDL数(プライマリ) | NT |
| マイコプラズマ検出 | - | 細菌汚染検出 | - |
| 真菌汚染検出 | - | アイソザイム検査・動物名 | NT |
| 染色体モード | NT | 染色体情報 | NT |
| 表面抗原 | NT | DNA Profile (STR) | |
| 接着性 | No | 導入外部遺伝子 | NT |
| 凍結培地 | 炭酸ガス濃度 | ||
| 解凍後生細胞率 | 追加情報 |
| 細胞番号 | JCRB0085 | 細胞名 | HL60 |
|---|---|---|---|
| 培養ロット番号 | 091792 | 培養種別 | distribution |
| 培地 | RPMI1640 medium (081792) with 10% fetal bovine serum (Hyclone 11151031) | 培養温度 | 37 C |
| 継代時細胞数(濃度) | 1.1-1.5x10^5 cells/ml | 継代方法 | Simple dilution |
| 増殖速度 | NT | 凍結時生細胞濃度 | 1.37x10^6 |
| 凍結時生細胞率 | 94.9 | 使用抗生物質 | free |
| 継代数 | P7* =correct. | PDL数(プライマリ) | NT |
| マイコプラズマ検出 | - | 細菌汚染検出 | - |
| 真菌汚染検出 | - | アイソザイム検査・動物名 | NT |
| 染色体モード | M=46 | 染色体情報 | NT |
| 表面抗原 | NT | DNA Profile (STR) | |
| 接着性 | No | 導入外部遺伝子 | NT |
| 凍結培地 | Culture medium with 5% DMSO. | 炭酸ガス濃度 | |
| 解凍後生細胞率 | 追加情報 |
| Images |
|---|
 |
| 細胞番号 | JCRB0085 | 細胞名 | HL60 |
|---|---|---|---|
| 培養ロット番号 | 042092 | 培養種別 | distribution |
| 培地 | RPMI1640(lot.021992,041592)+10% FBS(lot.Cell Cult.Lab. 0099-01) | 培養温度 | 37 C |
| 継代時細胞数(濃度) | 3x10^4 cells/sq.cm | 継代方法 | dilution |
| 増殖速度 | NT | 凍結時生細胞濃度 | 8.9x10^6 |
| 凍結時生細胞率 | 86.9 | 使用抗生物質 | free |
| 継代数 | P7* | PDL数(プライマリ) | NT |
| マイコプラズマ検出 | - | 細菌汚染検出 | - |
| 真菌汚染検出 | - | アイソザイム検査・動物名 | NT |
| 染色体モード | NT | 染色体情報 | NT |
| 表面抗原 | NT | DNA Profile (STR) | |
| 接着性 | No | 導入外部遺伝子 | NT |
| 凍結培地 | 炭酸ガス濃度 | ||
| 解凍後生細胞率 | 追加情報 |
| 細胞番号 | JCRB0085 | 細胞名 | HL60 |
|---|---|---|---|
| 培養ロット番号 | 062091 | 培養種別 | distribution |
| 培地 | RPMI1640 + 10 % FBS | 培養温度 | 37 |
| 継代時細胞数(濃度) | 1-2x10^5 cells/ml | 継代方法 | Dilution subculture |
| 増殖速度 | NT | 凍結時生細胞濃度 | 1x10^6 |
| 凍結時生細胞率 | 97.4 | 使用抗生物質 | free |
| 継代数 | P6* | PDL数(プライマリ) | NT |
| マイコプラズマ検出 | - | 細菌汚染検出 | - |
| 真菌汚染検出 | - | アイソザイム検査・動物名 | NT |
| 染色体モード | NT | 染色体情報 | NT |
| 表面抗原 | NT | DNA Profile (STR) | |
| 接着性 | No | 導入外部遺伝子 | NT |
| 凍結培地 | 炭酸ガス濃度 | ||
| 解凍後生細胞率 | 追加情報 |
| 細胞番号 | JCRB0085 | 細胞名 | HL60 |
|---|---|---|---|
| 培養ロット番号 | 090790 | 培養種別 | distribution |
| 培地 | RPMI1640 + FCS 10% | 培養温度 | 37 |
| 継代時細胞数(濃度) | 1-2x10^5 cells/ml | 継代方法 | Dilute by fresh medium, and subculture every 6-7 days. |
| 増殖速度 | NT | 凍結時生細胞濃度 | 5.0x10^6 |
| 凍結時生細胞率 | NT | 使用抗生物質 | free |
| 継代数 | P7 | PDL数(プライマリ) | |
| マイコプラズマ検出 | NT | 細菌汚染検出 | NT |
| 真菌汚染検出 | NT | アイソザイム検査・動物名 | NT |
| 染色体モード | 染色体情報 | NT | |
| 表面抗原 | DNA Profile (STR) | ||
| 接着性 | 導入外部遺伝子 | ||
| 凍結培地 | 炭酸ガス濃度 | ||
| 解凍後生細胞率 | 追加情報 |
| 細胞番号 | JCRB0085 | 細胞名 | HL60 |
|---|---|---|---|
| 培養ロット番号 | 051590 | 培養種別 | distribution |
| 培地 | RPMI1640 + FCS 10% | 培養温度 | 37 |
| 継代時細胞数(濃度) | 1-2x10^5 cells/ml | 継代方法 | Dilute by fresh medium, and subculture every 6-7 days. |
| 増殖速度 | NT | 凍結時生細胞濃度 | 2.5x10^6 |
| 凍結時生細胞率 | NT | 使用抗生物質 | free |
| 継代数 | P8 | PDL数(プライマリ) | |
| マイコプラズマ検出 | NT | 細菌汚染検出 | NT |
| 真菌汚染検出 | NT | アイソザイム検査・動物名 | NT |
| 染色体モード | 染色体情報 | NT | |
| 表面抗原 | DNA Profile (STR) | ||
| 接着性 | 導入外部遺伝子 | ||
| 凍結培地 | 炭酸ガス濃度 | ||
| 解凍後生細胞率 | 追加情報 |
| 細胞番号 | JCRB0085 | 細胞名 | HL60 |
|---|---|---|---|
| 培養ロット番号 | 101189 | 培養種別 | distribution |
| 培地 | RPMI1640 + FCS 10% | 培養温度 | 37 |
| 継代時細胞数(濃度) | 1-2x10^5 cells/ml | 継代方法 | Dilute by fresh medium, and subculture every 6-7 days. |
| 増殖速度 | NT | 凍結時生細胞濃度 | 2.7x10^6 |
| 凍結時生細胞率 | NT | 使用抗生物質 | free |
| 継代数 | P7* | PDL数(プライマリ) | |
| マイコプラズマ検出 | - | 細菌汚染検出 | - |
| 真菌汚染検出 | - | アイソザイム検査・動物名 | NT |
| 染色体モード | 染色体情報 | NT | |
| 表面抗原 | DNA Profile (STR) | ||
| 接着性 | 導入外部遺伝子 | ||
| 凍結培地 | 炭酸ガス濃度 | ||
| 解凍後生細胞率 | 追加情報 |
| 細胞番号 | JCRB0085 | 細胞名 | HL60 |
|---|---|---|---|
| 培養ロット番号 | 080687 | 培養種別 | distribution |
| 培地 | RPMI1640 + FCS 10% | 培養温度 | 37 |
| 継代時細胞数(濃度) | 1-2x10^5 cells/ml | 継代方法 | Dilute by fresh medium, and subculture every 6-7 days. |
| 増殖速度 | NT | 凍結時生細胞濃度 | 9x10^5 |
| 凍結時生細胞率 | NT | 使用抗生物質 | free |
| 継代数 | P6* | PDL数(プライマリ) | |
| マイコプラズマ検出 | - | 細菌汚染検出 | - |
| 真菌汚染検出 | - | アイソザイム検査・動物名 | G6PD,LD,NP |
| 染色体モード | 染色体情報 | NT | |
| 表面抗原 | DNA Profile (STR) | ||
| 接着性 | 導入外部遺伝子 | ||
| 凍結培地 | 炭酸ガス濃度 | ||
| 解凍後生細胞率 | 追加情報 |
| 細胞番号 | JCRB0085 | 細胞名 | |
|---|---|---|---|
| 培養ロット番号 | 043097 | 培養種別 | distribution |
| 培地 | RPMI1640 with 20% fetal bovine serum(FBSは熱非働化を推奨)。対数増殖期にはFBS10%にて培養可能。 | 培養温度 | 37 C |
| 継代時細胞数(濃度) | ca 2 x 10^5 cells/ml | 継代方法 | 希釈。解凍時は5mlの培地から御培養下さい。フラスコ を傾け細胞を寄集めた状態で培養すると立上りが良好。 |
| 増殖速度 | 凍結時生細胞濃度 | 1.9 x 10^6 | |
| 凍結時生細胞率 | 93.0 | 使用抗生物質 | free |
| 継代数 | P13* | PDL数(プライマリ) | |
| マイコプラズマ検出 | - | 細菌汚染検出 | - |
| 真菌汚染検出 | - | アイソザイム検査・動物名 | confirmed as human by NP, G6PD (type B), MD. |
| 染色体モード | 染色体情報 | ||
| 表面抗原 | DNA Profile (STR) | ||
| 接着性 | No | 導入外部遺伝子 | |
| 凍結培地 | 炭酸ガス濃度 | ||
| 解凍後生細胞率 | 追加情報 |
| 細胞番号 | JCRB0085 | 細胞名 | HL60 |
|---|---|---|---|
| 培養ロット番号 | 02082016 | 培養種別 | distribution |
| 培地 | RPMI1640 medium with 20% fetal bovine serum (FBS; GIBCO Cat. # 10091). | 培養温度 | 37 C |
| 継代時細胞数(濃度) | 2.6 - 2.8 x 10^5 cells/mL | 継代方法 | Simple dilution. (Slant culture to achieve local high cell density on first seeding) |
| 増殖速度 | approx. 31 hrs. | 凍結時生細胞濃度 | 3.6 x 10^6 |
| 凍結時生細胞率 | 84 | 使用抗生物質 | free |
| 継代数 | Unknown (11 at bank) | PDL数(プライマリ) | |
| マイコプラズマ検出 | - | 細菌汚染検出 | - |
| 真菌汚染検出 | - | アイソザイム検査・動物名 | NT |
| 染色体モード | 染色体情報 | ||
| 表面抗原 | DNA Profile (STR) | ||
| 接着性 | No | 導入外部遺伝子 | |
| 凍結培地 | 10% DMSO, 20% FBS - RPMI1640 | 炭酸ガス濃度 | 5% |
| 解凍後生細胞率 | 84 | 追加情報 |
| 細胞番号 | JCRB0085 | 細胞名 | HL60 |
|---|---|---|---|
| 培養ロット番号 | 02152018 | 培養種別 | distribution |
| 培地 | RPMI1640 medium with 20% fetal bovine serum (FBS; Sigma Cat. # 172012). | 培養温度 | 37 C |
| 継代時細胞数(濃度) | 0.7 - 1.3 x 10^5 cells/mL | 継代方法 | Simple dilution (suspension culture). (解凍時はフラスコを傾けて細胞を角に集めて培養すると増殖の立ち上がりが早いです To improve first growth, the flask should be slant slightly to gather cells to the corner. ) |
| 増殖速度 | approx. 27 hrs. | 凍結時生細胞濃度 | 4.9 x 10^6 |
| 凍結時生細胞率 | 90.1 | 使用抗生物質 | free |
| 継代数 | Unknown (15 at bank) | PDL数(プライマリ) | |
| マイコプラズマ検出 | - | 細菌汚染検出 | - |
| 真菌汚染検出 | - | アイソザイム検査・動物名 | |
| 染色体モード | 染色体情報 | ||
| 表面抗原 | DNA Profile (STR) | ||
| 接着性 | No | 導入外部遺伝子 | |
| 凍結培地 | 10% DMSO, 20% FBS - RPMI1640 | 炭酸ガス濃度 | 5% |
| 解凍後生細胞率 | 90.1 | 追加情報 |
| 細胞番号 | JCRB0085 | 細胞名 | HL60 |
|---|---|---|---|
| 培養ロット番号 | 04092019 | 培養種別 | distribution |
| 培地 | RPMI 1640 medium with 20% fetal bovine serum (FBS; Sigma Cat. # 172012). | 培養温度 | 37 C |
| 継代時細胞数(濃度) | approx. 1.5 x 10^5 cells/mL | 継代方法 | Simple dilution (suspension culture). (解凍時はフラスコを傾けて細胞を角に集めて培養すると増殖の立ち上がりが早いです To improve first growth, the flask should be slant slightly to gather cells to the corner. ) |
| 増殖速度 | approx. 32 hrs. | 凍結時生細胞濃度 | 2.8 x 10^6 |
| 凍結時生細胞率 | 91.7 | 使用抗生物質 | free |
| 継代数 | Unknown (10 at bank) | PDL数(プライマリ) | |
| マイコプラズマ検出 | - | 細菌汚染検出 | - |
| 真菌汚染検出 | - | アイソザイム検査・動物名 | |
| 染色体モード | 染色体情報 | ||
| 表面抗原 | DNA Profile (STR) | ||
| 接着性 | No | 導入外部遺伝子 | |
| 凍結培地 | 10% DMSO, 20% FBS - RPMI 1640 | 炭酸ガス濃度 | 5% |
| 解凍後生細胞率 | 83.0 | 追加情報 |
| 細胞番号 | JCRB0085 | 細胞名 | HL60 |
|---|---|---|---|
| 培養ロット番号 | 07072022 | 培養種別 | distribution |
| 培地 | RPMI 1640 medium with 20% fetal bovine serum (FBS; Biowest Cat. # S1820-500). | 培養温度 | 37 C |
| 継代時細胞数(濃度) | 1 - 3 x 10^5 cells/mL | 継代方法 | Simple dilution (suspension culture). (解凍時はフラスコを傾けて細胞を角に集めて培養すると増殖の立ち上がりが早いです To improve first growth, the flask should be slant slightly to gather cells to the corner. ) |
| 増殖速度 | approx. 34 hrs. | 凍結時生細胞濃度 | 4.9 x 10^6 |
| 凍結時生細胞率 | 96 | 使用抗生物質 | free |
| 継代数 | Unknown (12 at bank) | PDL数(プライマリ) | |
| マイコプラズマ検出 | - | 細菌汚染検出 | - |
| 真菌汚染検出 | - | アイソザイム検査・動物名 | |
| 染色体モード | 染色体情報 | ||
| 表面抗原 | DNA Profile (STR) | D5S818:12 D13S317:8,11 D7S820:11,12 D16S539:11 VWA:16 TH01:7,8 AM:X TPOX:8,11 CSF1PO:13,14 |
|
| 接着性 | No | 導入外部遺伝子 | |
| 凍結培地 | 10% DMSO, 20% FBS - RPMI1640 | 炭酸ガス濃度 | 5% |
| 解凍後生細胞率 | 91 | 追加情報 |
| 細胞番号 | JCRB0085 | 細胞名 | HL60 |
|---|---|---|---|
| 培養ロット番号 | 02122025 | 培養種別 | distribution |
| 培地 | RPMI 1640 medium with 20% fetal bovine serum (FBS; Nichirei Cat. # 174112, Lot 20M00K) | 培養温度 | 37 C |
| 継代時細胞数(濃度) | 0.8 - 5.3 x 10^5 cells/mL | 継代方法 | Simple dilution (suspension culture). (解凍時はフラスコを傾けて細胞を角に集めて培養すると増殖の立ち上がりが早いです To improve first growth, the flask should be slant slightly to gather cells to the corner. ) |
| 増殖速度 | 32 - 42 hrs. | 凍結時生細胞濃度 | 3.2 x 10^6 |
| 凍結時生細胞率 | 90.2 | 使用抗生物質 | free |
| 継代数 | Unknown (10 at bank) | PDL数(プライマリ) | |
| マイコプラズマ検出 | - | 細菌汚染検出 | - |
| 真菌汚染検出 | - | アイソザイム検査・動物名 | |
| 染色体モード | 染色体情報 | ||
| 表面抗原 | DNA Profile (STR) | D5S818:12 D13S317:8,11 D7S820:11,12 D16S539:11 VWA:16 TH01:7,8 AM:X TPOX:8,11 CSF1PO:13,14 |
|
| 接着性 | No | 導入外部遺伝子 | |
| 凍結培地 | 10% DMSO, 20% FBS - RPMI1640 | 炭酸ガス濃度 | 5% |
| 解凍後生細胞率 | 80.4 | 追加情報 |
| 細胞番号 | JCRB0085 | 細胞名 | HL60 |
|---|---|---|---|
| 培養ロット番号 | 12182025 | 培養種別 | distribution |
| 培地 | RPMI1640(GIBCO Cat #11875-093) with 20% fetal bovine serum (Nichirei Cat. # 174112, Lot 20M00K) | 培養温度 | 37 C |
| 継代時細胞数(濃度) | 2.9-3.1x10^5 cells/mL | 継代方法 | dilution |
| 増殖速度 | NT | 凍結時生細胞濃度 | 2.0x10^6 |
| 凍結時生細胞率 | 97 | 使用抗生物質 | free |
| 継代数 | p11* | PDL数(プライマリ) | NT |
| マイコプラズマ検出 | - | 細菌汚染検出 | - |
| 真菌汚染検出 | - | アイソザイム検査・動物名 | NT |
| 染色体モード | NT | 染色体情報 | NT |
| 表面抗原 | NT | DNA Profile (STR) | D5S818:12 D13S317:8,11 D7S820:11,12 D16S539:11 VWA:16 TH01:7,8 AM:X TPOX:8,11 CSF1PO:13,14 |
| 接着性 | No | 導入外部遺伝子 | NT |
| 凍結培地 | BAMBANKER (LYMPHOTEC Inc., CS-02-001, NIPPON Genetics Co., LTD) | 炭酸ガス濃度 | 5% |
| 解凍後生細胞率 | 87 | 追加情報 |
| Images |
|---|
|